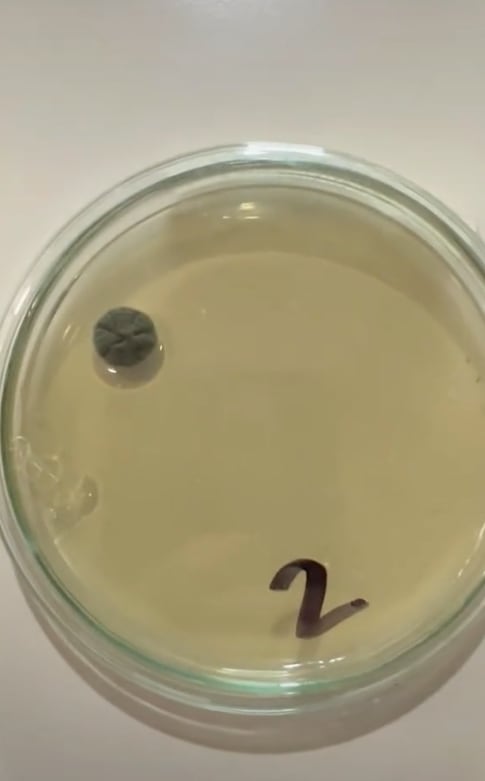
Experimento bacterias en Metro de la CDMX

¿Sabes cuál es el lugar más seguro para agarrarse en el Metro de la CDMX? Aquí te lo revelamos con base en un experimento casero.
La cuenta de TikTok @preguntalealbiologo, respondió a la pregunta de qué zona es la que debes evitar agarrar por la presencia de bacterias.
Luego de hacer pruebas en los torniquetes, tubos y máquinas de recarga, ahora sabemos qué zona del es la más contaminada y peligrosa del Metro.
El tubo horizontal del Metro es “una porquería”
La cuenta de TikTok @preguntalealbiologo, realizó un experimento casero en la línea naranja del Metro de la CDMX.
Esto, a razón de descubrir qué parte del Metro debemos evitar agarrar por la presencia de bacterias y hongos.

El experimento tardó 1 mes en arrojar sus resultados, y vaya que estos son increíbles y un tanto espeluznantes.
A decir de la bióloga encargada del estudio, se tomaron muestras de 6 partes del Metro que es muy común tocar.
- Barandal de las escaleras
- Máquinas de recarga
- Torniquetes
- Tubo horizontal en el vagón
- Tubo de la puerta en el vagón
- Tubo de los asientos en el vagón
Luego de 1 intento fallido y una semana de espera, el experimento resolvió la duda de qué parte del Metro está más contaminada.
De acuerdo con las pruebas, donde más bacterias crecieron fue el tubo horizontal que está dentro del vagón.
Por tanto, los usuarios del Metro deben evitar agarrarse de este a como de lugar.



“Esto si es una porquería, aquí hay diversidad de bacterias y hongos (...) hay 7 colonias.”
Usuaria de TikTok

Tubo de la puerta es el “más seguro” para agarrarse en el Metro
Mientras el tubo horizontal dentro del vagón es el más contaminado con hongos y bacterias, hay otras zonas del Metro que parecen ser “más seguras”.
Y es que, según se muestra en el video, el tubo de la puerta y del asiento estaban limpios de microorganismos.
“El tubo de la puerta parece ser que no creció prácticamente nada; el tubo del asiento igual.”
Usuaria de TikTok

Por su parte, el barandal de las escaleras y el torniquete, apenas alcanzaron a desarrollar micro colonias de bacterias y hongos.
En la máquina de recarga del Metro, en contraste, creció “una colonia más grande de hongos (...) y una ligera colonia de bacterias.”
@preguntalealbiologo Encontramos estos microbios en el metro 🤢 #aprendeentiktok #experimentos #porlaciencia #cienciaentiktok #metroCDMX ♬ sonido original - Pregúntale al Biólogo
Los comentarios al video de qué lugar debes evitar agarrar en el Metro, mencionaron algunas hipótesis sobre los resultados.
Algunos internautas mencionaron que la limpieza de algunas zonas se debe a la “desinfección por la pandemia”.
Otros más, dijeron desconfiar del experimento porque “no hay lugares limpios” en el Metro.